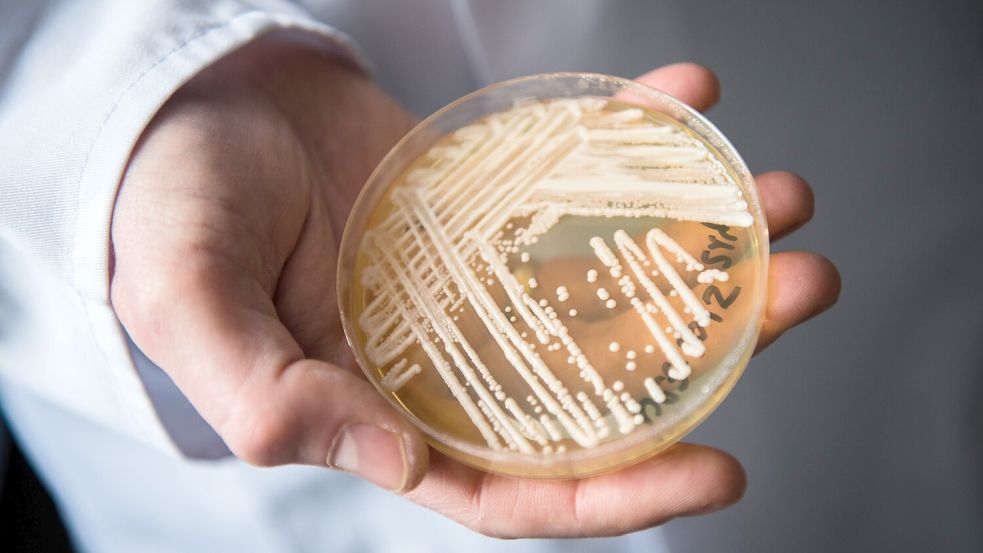
Eine Petrischale mit dem Hefepilz Candida auris. Foto: Nicolas Armer/dpa

Krankheitserreger Gefährlicher Pilz breitet sich aus

Eine Petrischale mit dem Hefepilz Candida auris. Foto: Nicolas Armer/dpa
Candida auris ist laut Experten „einer der bedrohlichsten Pilze unserer Zeit“. Er breitet sich weltweit aus. Auch die Krankenhäuser in der Region haben das Problem im Blick.
Lesedauer des Artikels: ca. 4 Minuten
Jetzt Artikel freischalten
Schnell bestellt – jederzeit kündbar.
- Voller Zugriff auf www.oz-online.de
- 700+ neue Artikel pro Woche
- OZ-App inklusive
3 Monate je
1€
statt 9,90 €
Du hast bereits ein OZ-Abo? Super!
Weitere Abo-Modelle